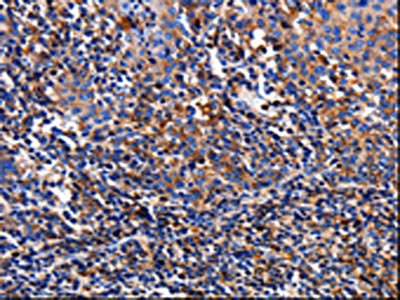

TTR Antibody
-
中文名稱:TTR兔多克隆抗體
-
貨號:CSB-PA143118
-
規(guī)格:¥1100
-
圖片:
-
The image on the left is immunohistochemistry of paraffin-embedded Human stomach cancer tissue using CSB-PA143118(TTR Antibody) at dilution 1/10, on the right is treated with fusion protein. (Original magnification: ×200)
-
The image on the left is immunohistochemistry of paraffin-embedded Human tonsil tissue using CSB-PA143118(TTR Antibody) at dilution 1/10, on the right is treated with fusion protein. (Original magnification: ×200)
-
-
其他:
產(chǎn)品詳情
-
Uniprot No.:
-
基因名:
-
別名:Amyloid polyneuropathy antibody; Amyloidosis I antibody; ATTR antibody; Carpal tunnel syndrome 1 antibody; CTS antibody; CTS1 antibody; Dysprealbuminemic euthyroidal hyperthyroxinemia antibody; Dystransthyretinemic hyperthyroxinemia antibody; Epididymis luminal protein 111 antibody; HEL111 antibody; HsT2651 antibody; PALB antibody; Prealbumin amyloidosis type I antibody; Prealbumin antibody; Prealbumin Thyroxine-binding antibody; Senile systemic amyloidosis antibody; TBPA antibody; Thyroxine binding prealbumin antibody; Transthyretin antibody; TTHY_HUMAN antibody; TTR antibody; TTR protein antibody
-
宿主:Rabbit
-
反應種屬:Human,Mouse,Rat
-
免疫原:Fusion protein of Human TTR
-
免疫原種屬:Homo sapiens (Human)
-
標記方式:Non-conjugated
-
抗體亞型:IgG
-
純化方式:Antigen affinity purification
-
濃度:It differs from different batches. Please contact us to confirm it.
-
保存緩沖液:-20°C, pH7.4 PBS, 0.05% NaN3, 40% Glycerol
-
產(chǎn)品提供形式:Liquid
-
應用范圍:ELISA,IHC
-
推薦稀釋比:
Application Recommended Dilution ELISA 1:1000-1:5000 IHC 1:25-1:100 -
Protocols:
-
儲存條件:Upon receipt, store at -20°C or -80°C. Avoid repeated freeze.
-
貨期:Basically, we can dispatch the products out in 1-3 working days after receiving your orders. Delivery time maybe differs from different purchasing way or location, please kindly consult your local distributors for specific delivery time.
-
用途:For Research Use Only. Not for use in diagnostic or therapeutic procedures.
相關(guān)產(chǎn)品
靶點詳情
-
功能:Thyroid hormone-binding protein. Probably transports thyroxine from the bloodstream to the brain.
-
基因功能參考文獻:
- familial amyloid polyneuropathy (FAP) carriers and patients are in an inflammatory state, with the presence of mutated TTR being a trigger of inflammation, especially in FAP carriers. PMID: 28484271
- In this review, we discussed the role of Ttr in CNS and its possible role in the neuroprotection mechanism of Semax. PMID: 30383932
- serum prealbumin, and its changes were independent predictors of worse prognosis in acute kidney injury (AKI), and could be potential surrogates to better predict 90-day mortality. PMID: 28145481
- T139R mutation may expose the buried regions of TTR protein which help in the self association and the increase in the stability may help in the TTR deposition. Structural analysis indicated that F and H strands of TTR are more prone to aggregation. Thus, T139R mutation might cause these residues to be aggregation prone and change in folding rate and validated TTR monomer in diseased cases by Western blot analysis. PMID: 29564986
- High TTR expression is associated with hypertriglyceridemia. PMID: 29747616
- Our study characterizes G101S TTR as a stable and N-glycosylable TTR, which may be linked to its non-amyloidogenic characteristic. G101S TTR had slower rate of tetramer dissociation and lower propensity for amyloid fibril formation, especially at mild low pH (4.2 and 4.5), and was likely to have strong hydrophobic interaction among TTR monomers, suggesting relatively higher stability of G101S TTR compared with WT TTR. PMID: 29607936
- studies of a unique duplication mutation explain its diflunisal-resistant nature, identify misfolding pathways for amyloidogenic TTR variants, and provide therapeutic targets to inhibit amyloid fibril formation by variant TTR. PMID: 29941560
- At physiological temperature, the monomeric intermediate formed by wild-type TTR under mildly acidic conditions rapidly aggregates into species that are invisible to NMR, leading to loss of the NMR signal at the same rate as the turbidity increase. PMID: 29915031
- We report here three non-related Hungarian cases of transthyretin familial amyloid polyneuropathy with non-Val30Met mutations (His88Arg in two cases, Phe33Leu in one case) PMID: 29465889
- A novel amyloidogenic TTR mutation was found in a Dutch family PMID: 28460244
- Patients with ATTRV30M amyloidosis in non-endemic areas and patients with non-V30M ATTR amyloidosis occurred more frequently than previously believed, and their clinical manifestations were diverse. PMID: 29177547
- Results indicate that TTR stability is important for its recently described functions in assisting Abeta transport at the BBB and at the liver and also in regulating LRP1 levels and activity. TTR stabilization can serve as an avenue to increase both Abeta elimination and LRP1 levels, which in turn will further participate in Abeta clearance. PMID: 28570028
- Findings are the first to show that TTR deposition increases disease severity in the murine DMM and aging model of OA. PMID: 28941045
- This study demonstrated that both cardiac and peripheral vasomotor autonomic dysfunctions were prevalent in late-onset FAP ATTR Val30Met patients from non-endemic areas, even in those without orthostatic intolerance. PMID: 28983659
- could potentially downregulate the TTR promoter activity; c.200+4A>G might influence the constitutive splicing of TTR mRNA PMID: 27562180
- Systematic computational prioritization identified a missense mutation c.G148T in TTR gene which results in a p.V50L substitution known to cause transthyretin-related familial amyloid polyneuropathy. PMID: 27212199
- This stuidy found two mutations, Thr49Ala(p.Thr69Ala) and Tyr116Ser(p.Tyr136 Ser), were detected in Chinese familial amyloid polyneuropathy patients for the first time. PMID: 27859927
- The results suggest an association between presumed nonamyloidogenic mutations in the TTR gene and the development of autonomic and small fiber neuropathy. PMID: 28556268
- Clinical, electrophysiological, histopathological, and genetic characteristics of 17 patients from Turkey (5 female, 13 male) from nine families with polyneuropathy and mutations in TTR were evaluated. Sequence analysis of the TTR gene revealed five mutations (Val30Met, Glu89Gln, Gly53Glu, Glu54Gly and Gly47Glu). Study suggests that a cohort of patients from Turkey with TTR-FAP exhibits clinical and genetic heterogeneity. PMID: 27238058
- It is one of the major Abeta-binding proteins acting as a neuroprotector in AD. In addition, TTR cleaves Abeta peptide in vitro. PMID: 28780366
- Stroke patients with lower transthyretin levels had poorer Functional Independence Measure outcomes and tended not to be discharged to their own homes. PMID: 28314625
- TTR expression varied across human populations PMID: 28335735
- Cell-based experiments showed that overexpression of TTR could improve HK-2 cell viability and inhibit apoptosis. PMID: 29040977
- These results clarify a negligible degree of unfolding of beta-strand C in the formation of the amyloidogenic state and establish the concept that TTR is a highly plastic protein able to populate at least three distinct conformational states. PMID: 28478513
- A strong phenotypic heterogeneity was demonstrated across coding mutations causing TTR amyloidosis. Non-coding variants affect TTR expression and, consequently, phenotypic presentation in carriers of amyloidogenic mutations. PMID: 28635949
- Serum prealbumin was significantly lower in patients with versus those without post-stroke depression, and was a significant predictor of post-stroke depression after adjusting for confounding risk factors. PMID: 27693925
- TTR induced apoptosis of retinal microvascular endothelial cells in an environment that simulated hypoxia. PMID: 28950253
- Data suggest that transthyretin exhibits site-specific solvation of the indole ring of tryptophans W41 and W79; these studies involved incorporation of tryptophan labeled with fluorine at 5 or 6 positions (5-fluorotryptophan/5FW or 6-fluorotryptophan/6FW) into recombinant TTR; replacement of fluorine at 5-position of a tryptophan with one at adjacent 6-position emphasizes delicate balance of stability in TTR tetramer. PMID: 28920433
- This study shows that highly destabilized, aggregation-prone TTR variants are secreted as both native tetramers and non-native conformations that accumulate as high-molecular-weight oligomers. PMID: 27720586
- The role of transthyretin in normal pregnancy is reviewed. PMID: 27650990
- the role of H88 and the hydrogen bond network in the stability of TTR PMID: 28563699
- we identify a somatic mosaicism, in several subjects affected by familial amyloidotic polyneuropathy, involving the dominant c.325G>C mutation of the TTR gene PMID: 28508289
- The role of Transthyretin in the regulation of Ubc9 SUMOylation PMID: 27501389
- Gene sequencing revealed a phenylalanine-->isoleucine mutation in the 33rd position of exon 2 of TTR in 1 patient of 1 pedigree, confirming the diagnosis of FAP. Two patients subsequently were found to have sensorimotor autonomic neuropathy, whereas 2 others had subclinical autonomic dysfunction. PMID: 28412068
- TTR V30M aggregates and autophagy impairment are associated with Transthyretin amyloidoses . PMID: 27382986
- In Afro-Caribbean patients living in London, ATTR V122I is an underappreciated cause of heart failure, and cardiomyopathy is often misattributed to hypertension. PMID: 27618855
- Val122Ile is the most common transthyretin mutation, and neurologic phenotypic expression differs between wild-type disease and Val122Ile, but survival from enrollment in THAOS does not. PMID: 27386769
- In the bound state, the Hsp90 dimer predominantly populates an open conformation, and transthyretin retains its globular structure. PMID: 28218749
- findings show that, at physiologically-relevant protein concentrations, the refolding pathways of WT-TTR and amyloidogenic variant V30M-TTR follow a common mechanism observed among other tetrameric proteins; although sharing the same kinetic mechanism, V30M-TTR refolds at a slower rate than WT-TTR, a feature that may favor the formation of transient species leading to kinetic partition into amyloidogenic pathways PMID: 27589730
- This study reports the discovery of a TTR mutant, N98A, that was more effective at inhibiting ABETA aggregation than wild-type (WT) TTR, although N98A and WT bound ABETA equally. PMID: 27099354
- Results provide evidence that TTR acts as a carrier of Abeta at the blood-brain-barrier and liver, using LRP1. PMID: 26837706
- The study reports a Japanese family with hereditary ATTR amyloidosis with the TTR G47R mutation in which one family member developed the disease at the age of 13. PMID: 27206384
- a point mutation was identified in the upstream regulatory region of the TTR gene in a Han Chinese family with familial vitreous amyloidosis. PMID: 27051017
- Data indicte that the use of polyethylene glycol (PEG) to crystallize transthyretin (TTR complexes have resulted in a new trigonal polymorph with two tetramers in the asymmetric unit. PMID: 26796656
- A novel autosomally inherited Lys90Glu mutation in the TTR gene in a family with vitreous amyloidosis and carpal tunnel syndrome. PMID: 26828956
- illustrates the diversity of symptoms encountered in homozygote ATTR V30M patients PMID: 26587769
- Caucasian patients with the Val142Ile pathogenic variant have phenotypic manifestations similar to African-Americans PMID: 26428663
- Data suggest that well-structured AB loop regions of TTR in native/homotetrameric/stable state become dissociated/disordered/unfolded at low pH; during refolding, structural perturbations in AB loop appear and facilitate misfolding and amyloid formation. PMID: 26998642
- Eight water molecules stabilize the dimeric structure through an extensive hydrogen-bonding network. PMID: 26527142
- Study elucidated alterations in TTR, APP and the global gene expression profile in the frontal cortex between idiopathic normal pressure hydrocephalus patients and nondemented control brain PMID: 26444765
顯示更多
收起更多
-
相關(guān)疾病:Amyloidosis, transthyretin-related (AMYL-TTR); Hyperthyroxinemia, dystransthyretinemic (DTTRH); Carpal tunnel syndrome 1 (CTS1)
-
亞細胞定位:Secreted. Cytoplasm.
-
蛋白家族:Transthyretin family
-
組織特異性:Detected in serum and cerebrospinal fluid (at protein level). Highly expressed in choroid plexus epithelial cells. Detected in retina pigment epithelium and liver.
-
數(shù)據(jù)庫鏈接:
Most popular with customers
-
-
YWHAB Recombinant Monoclonal Antibody
Applications: ELISA, WB, IHC, IF, FC
Species Reactivity: Human, Mouse, Rat
-
Phospho-YAP1 (S127) Recombinant Monoclonal Antibody
Applications: ELISA, WB, IHC
Species Reactivity: Human
-
-
-
-
-